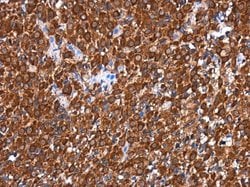
Invitrogen RGS6 Polyclonal Antibody 100 &mu;L; Unconjugated:Antibodies,

missing translation for 'onlineSavingsMsg'
Learn More
Learn More
Invitrogen™ RGS6 Polyclonal Antibody


Rabbit Polyclonal Antibody
Brand: Invitrogen™ PA530876
This item is not returnable.
View return policy
Description
Recommended positive controls: PC-3. Predicted reactivity: Mouse (96%), Rat (97%), Xenopus laevis (81%), Chicken (92%), Rhesus Monkey (98%). Store product as a concentrated solution. Centrifuge briefly prior to opening the vial.
Members of the RGS (regulator of G protein signaling) family, such as RGS6, modulate G protein function by activating the intrinsic GTPase activity of the alpha (guanine nucleotide-binding) subunits (Seki et al., 1999 [PubMed 10083744]).
Specifications
| RGS6 | |
| Polyclonal | |
| Unconjugated | |
| RGS6 | |
| DKFZp313G1241; FLJ43552; GAP; H_DJ1108A12.1; MGC142132; regulator of G-protein signaling 6; regulator of G-protein signalling 6; RGS6; S914; WUGSC:H_DJ0283M22.1; WUGSC:H_DJ1108A12.1 | |
| Rabbit | |
| Antigen affinity chromatography | |
| RUO | |
| 54295, 9628 | |
| Store at 4°C short term. For long term storage, store at -20°C, avoiding freeze/thaw cycles. | |
| Liquid |
| Immunohistochemistry (Paraffin), Western Blot | |
| 1 mg/mL | |
| PBS with 20% glycerol and 0.01% thimerosal; pH 7 | |
| P49758, P49801 | |
| RGS6 | |
| Recombinant protein encompassing a sequence within the center region of human RGS6. The exact sequence is proprietary. | |
| 100 μL | |
| Primary | |
| Human, Rat | |
| Antibody | |
| IgG |
Product Content Correction
Your input is important to us. Please complete this form to provide feedback related to the content on this product.
Product Title
Spot an opportunity for improvement?Share a Content Correction